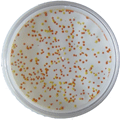
072201.png

測試菌株:地衣芽孢桿菌
用途:蛋白酶生產(chǎn) 培養(yǎng)基成分:玉米粉和豆餅粉總組分15%,121℃滅菌25min,PH值7.5
培養(yǎng)基成分:玉米粉和豆餅粉總組分15%,121℃滅菌25min,PH值7.5
其他表面活性劑:無測試方法和結(jié)果:開始發(fā)酵前對培養(yǎng)基滅菌。滅菌前在培養(yǎng)基中添加發(fā)酵消泡劑,滅菌后以2%接種量接種。發(fā)酵過程分發(fā)酵前期和發(fā)酵后期。在發(fā)酵前期,產(chǎn)生的泡沫始終在2厘米厚度左右,無氣泡沖頂現(xiàn)象。在發(fā)酵后期,添加少量THIX-298發(fā)酵消泡劑泡沫立刻消退,表現(xiàn)出良好的消泡和抑泡效果,降低泡沫厚度,維持至發(fā)酵結(jié)束。由此得出:THIX-298發(fā)酵消泡劑具有良好的消泡和抑泡性能,既能在發(fā)酵初期控制泡沫,又可在發(fā)酵后期控制泡沫。性能與分析:試驗中,THIX-298發(fā)酵用消泡劑使用量在千分之三即可有效消泡和抑泡,能滿足芽孢桿菌發(fā)酵需要。原因是298發(fā)酵消泡劑具有優(yōu)良的疏水性,通常,發(fā)酵消泡劑疏水性越高,抑制泡沫生成時間就越長,這意味著使用量就越少,使用過程中消泡速度和抑泡效果都很好。由于此次試驗屬高密度發(fā)酵水平,底物濃度高,在發(fā)酵過程中微生物生長和底物消耗會導致液體流變學特性改變,所以要求發(fā)酵消泡劑要有足夠的消泡能力,既能在發(fā)酵初期消泡,也能在微生物高峰期消泡。 THIX-298發(fā)酵消泡劑是專業(yè)用于發(fā)酵領(lǐng)域的具有國際先進水平的消泡劑,運用最新消、抑泡理論和技術(shù),經(jīng)特殊工藝生產(chǎn)而成,具有優(yōu)良的消抑泡效果,耐高溫,耐酸堿,無副作用,可提高收率水平,發(fā)酵后期提取簡單。根據(jù)發(fā)酵工藝特點,298發(fā)酵消泡劑可在發(fā)酵基礎(chǔ)料中添加,也可在高溫滅菌后流加,或者混合植物油添加。發(fā)酵用消泡劑適用于生物、醫(yī)藥等發(fā)酵工藝,如各類抗生素、頭胞、酶制劑、青霉素、鏈霉素、谷氨酸、賴氨酸、氨基酸、檸檬酸、維生素C、阿維菌素、慶大霉素、酒精、酵母、井崗霉素、卡那霉素、黃原膠、大豆蛋白及芽胞菌等各種菌種的生產(chǎn)發(fā)酵過程的消泡。在食品加工、工業(yè)制糖、消除其它的水相泡沫等工業(yè)的消泡。本文簡要介紹THIX-298發(fā)酵消泡劑在芽孢桿菌高密度發(fā)酵中效果試驗,如有任何問題可致電298發(fā)酵消泡劑專業(yè)生產(chǎn)廠家煙臺恒鑫化工05358015296,可提供樣品試用。
THIX-298發(fā)酵消泡劑是專業(yè)用于發(fā)酵領(lǐng)域的具有國際先進水平的消泡劑,運用最新消、抑泡理論和技術(shù),經(jīng)特殊工藝生產(chǎn)而成,具有優(yōu)良的消抑泡效果,耐高溫,耐酸堿,無副作用,可提高收率水平,發(fā)酵后期提取簡單。根據(jù)發(fā)酵工藝特點,298發(fā)酵消泡劑可在發(fā)酵基礎(chǔ)料中添加,也可在高溫滅菌后流加,或者混合植物油添加。發(fā)酵用消泡劑適用于生物、醫(yī)藥等發(fā)酵工藝,如各類抗生素、頭胞、酶制劑、青霉素、鏈霉素、谷氨酸、賴氨酸、氨基酸、檸檬酸、維生素C、阿維菌素、慶大霉素、酒精、酵母、井崗霉素、卡那霉素、黃原膠、大豆蛋白及芽胞菌等各種菌種的生產(chǎn)發(fā)酵過程的消泡。在食品加工、工業(yè)制糖、消除其它的水相泡沫等工業(yè)的消泡。本文簡要介紹THIX-298發(fā)酵消泡劑在芽孢桿菌高密度發(fā)酵中效果試驗,如有任何問題可致電298發(fā)酵消泡劑專業(yè)生產(chǎn)廠家煙臺恒鑫化工05358015296,可提供樣品試用。
手機:18396600176 電話:0535-8015296 EMAIL:[email protected]
公司地址:山東省煙臺市開發(fā)區(qū)武漢大街19號
?2016恒鑫化工 魯ICP備05045800號-13 xml地圖
聯(lián)系電話
微信掃一掃
